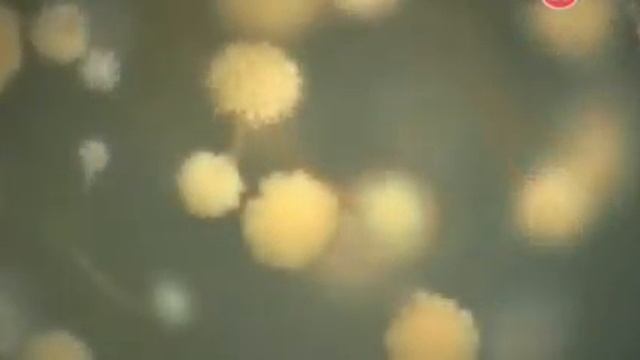
Наука разложения 1 смотреть онлайн

Автор: Грибная драма Страница 3

Наша барыня на Масленице)))

BIGSHER feat Serik Ibragimov - No Love

Выпускной

The heat is on; cooling down the response to Aspergillus

The road through Akkol to the Forestry - Дорога через Акколь в Лесхоз

QSAR antibiotik

Arena vs apoc and 4 horsemen

Dadas Man - Картошка (пародия)

ТОП 50 БИЛЛБОРД | ЗАРУБЕЖНЫЕ ХИТЫ | ТОП ЗАРУБЕЖНЫХ ПЕСЕН

How to make spring rolls at home - vegetarian - vegan recipe

СЕКРЕТ РЕЦЕПТА - ШОКОЛАДНЫЕ КОНФЕТЫ ТРЮФЕЛИ. ГОТОВИМ САМИ!

ТЕСТ шлема шамана в одине, УРОН НА МАКСИМУМ! #frostborn #frostbornpvp #фростборн

pombe

Играю в игру Существа Сонарии за Йотунхеля!

Охота На Маслят | Dayz Standalone (1pp)

Троюродный брат инцестник

Власова Эллина.ВОКАЛ" ГРИБЫ" дк МОТОРОСТРОИТЕЛЕЙ Г. БАРНАУЛ ОФИЦИАЛЬНОЕ ВИДЕО ЛАУРЕАТ 3 СТЕПЕНИ
Наука разложения 1

Собираем грибы.

Итоги, часть 2. Стоимость пользования сотовым телефоном.

Сборка Шиповника

Рыжий гриб

Успешные люди #0 Пилот. КАК ВЫРАСТИТЬ МНОГО ГРИБОВ?

ВДНХ мега форм Владимир Полежаев милиордер шведской компании орифлайм!
За каждым успешным каналом стоит личность, идея и сотни часов кропотливого труда. Если вы здесь, значит, автор «Грибная драма» уже сумел зацепить ваше внимание своим уникальным стилем или подачей. А мы на RUVIDEO позаботились о том, чтобы вы могли изучить весь архив его работ в максимально комфортных условиях — без лишней суеты и преград.
Почему за работами канала «Грибная драма» так интересно наблюдать? Всё просто: это честный контент, который находит отклик в сердцах зрителей. На нашем ресурсе вы можете смотреть онлайн все видео любимого автора бесплатно и в хорошем качестве. Нам важно, чтобы вы видели каждую деталь и слышали каждый нюанс, поэтому мы используем только стабильные плееры из открытых источников Rutube.
Следите за новинками канала, пересматривайте старые шедевры и открывайте для себя новые грани творчества «Грибная драма». Мы постоянно обновляем ленту, чтобы у вас под рукой всегда были самые свежие выпуски. Никаких сложных регистраций — только вы и творчество, которое вдохновляет. Приятного вам путешествия по миру авторского контента на RUVIDEO!
Видео взято из открытых источников Rutube. Если вы правообладатель, обратитесь к первоисточнику.